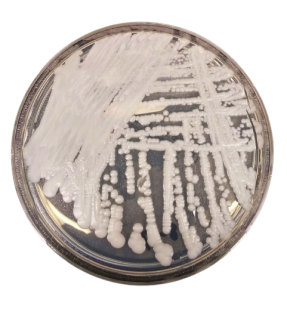
Candida auris colonies - Candida auriscolonies

Candida auris (C. auris) causes a serious and sometimes fatal fungal infection that is emerging globally. First identified in 2009 in Asia, this drug-resistant fungi is an emerging threat especially to vulnerable patients (e.g, hospitalized patients). C. auris infections have been reported in over 30 countries, including the United States.

This reported number may be just the ‘tip of the iceberg’ because the identification of C. auris requires specialized laboratory methods. It is presumed that infections might have spread occurred in many countries but identification or reporting may be lacking. Whole-genome sequencing findings suggest that C. aurishas emerged independently in multiple regions at roughly the same time.
Serious Global Health Threat
C. auris is an emerging drug-resistant fungus that presents a serious global health threat. According to CDC, it is concerned about C. auris for three main reasons:
- C. aurisis often resistant to antifungal drugs with some strains (types) resistant to all three major classes of antifungals.
- It has caused outbreaks in healthcare settings. Some common healthcare disinfectants are less effective at eliminating it. For this reason, it is important to quickly identify C. auris in a hospitalized patient so that healthcare facilities can take special precautions to stop its spread.
- Identifying C. auriswith standard laboratory methods is difficult. It can be misidentified as another type of Candida infection, in labs without specific technology. Misidentification may lead to inappropriate management, making it difficult to control the spread of C. auris in healthcare settings.
Transmission
C. auris can spread in healthcare settings through contact with contaminated environmental surfaces or equipment, or from person to person.
People at risk
Patients who have been hospitalized in a healthcare facility a long time, have a central venous catheter, or other lines or tubes entering their body, or have previously received antibiotics or antifungal medications, appear to be at the highest risk of infection with this yeast.
Infections caused byC. auris
- Blood stream infection (in some patients it can spread throughout the body causing serious invasive infections).
- Wound infection
- Ear infection
C. aurisgot its name because it was isolated from a patient with an ear infection in Japan.Aurisis the Latin word for ear.
More than 1 in 3 patients with invasive C. auris infection (for example, an infection that affects the blood, heart, or brain) die. It also has been isolated from respiratory and urine specimens, but it is unclear if it causes infections in the lung or bladder.
Laboratory Diagnosis
Sample: Blood or other body fluids
Culture
Culture is the commonly used method but identification of C. aurius from other types of yeasts, particularly Candida haemulonii is confusing. C. auris can be misidentified as other species of Candidawhen using traditional phenotypic methods for yeast identification such as VITEK 2 YST, API 20C, BD Phoenix yeast identification system, and MicroScan. Find more information about the identification ofC. auriushere.
MALDI-TOF
Special laboratory tests are needed to identify C. auris. Diagnostic devices based on matrix-assisted laser desorption/ionization time-of-flight (MALDI-TOF)can differentiate C. auris from other Candida species, but not all the reference databases included in MALDI-TOF devices allow for detection.
Treatment
Most C. aurisinfections are treatable with a class of antifungal drugs called echinocandins. However, some C. auris infections have been resistant to all three main classes of antifungal medications, making them more difficult to treat. In this situation, multiple classes of antifungals at high doses may be required to treat the infection.
References and further readings
- Candida auris | Candida auris | Fungal Diseases | CDC. (2021, May 5). https://www.cdc.gov/fungal/candida-auris/index.html
- Information for Laboratorians and Health Professionals | Candida auris | Fungal Diseases | CDC. (2019, July 11). https://www.cdc.gov/fungal/candida-auris/health-professionals.html